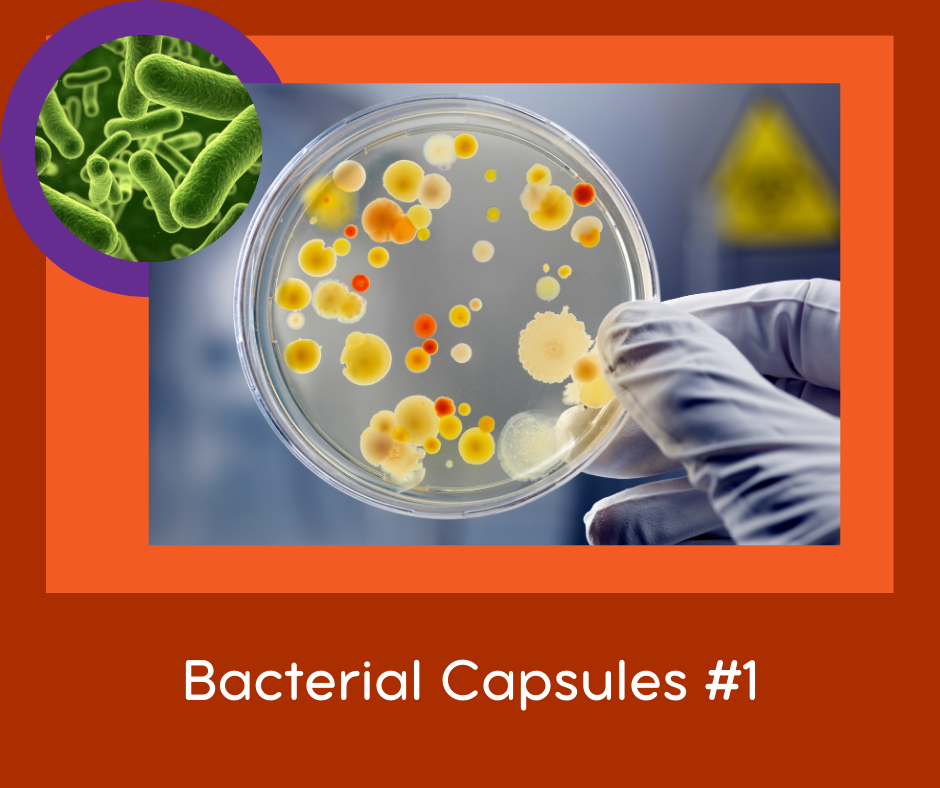

FSR for Bacterial Resonances:- The Bacterial Capsule
FSR's are sound files that, when played on your body, influence the vibration of your body. The result of this is that your system can have a positive change in response to the sound.
This is the Bactarial Capsule ResonanceTreatment file #1.
The bacterial capsule is a large structure common to many bacteria. It is a polysaccharide layer that lies outside the cell envelope, and is thus deemed part of the outer envelope of a bacterial cell. It is a well-organized layer, not easily washed off, and it can be the cause of various diseases
If diagnosed correctly, playing this FSR over your affected area can help stop the discomfort. You will need to play the FSR's for at least 10 min a day before any bacterial FSR you have.
Since the download is only beteeen 1 and 3 minutes long, you will need to loop it in a play list to reach the longer play times.
For the best result you need to play all the versions of meningitis and the biofilm FSR too.
Play this FSR with the headsets over your belly. This is a good item to add to you night list. (add it 10x to get the 30 min if you are using other FSR's too.)
Official Name: bacterial capsule

